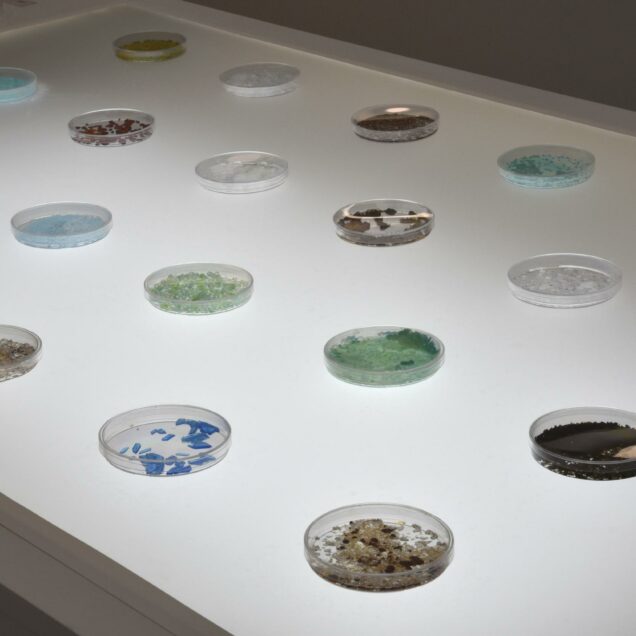

En collaboration avec le vivant
Entretien avec Chloé Jeanne

La pratique de Chloé Jeanne cherche à jouer avec nos perceptions et nos sens pour façonner de nouvelles relations au monde.
Née en 1994, Chloé Jeanne vit et travaille à Tours. Elle est diplômée avec les félicitations du jury de l’EESAB Quimper en juin 2018. Elle entreprend ensuite un post-diplôme recherche au sein de l’ECOLAB (ÉSAD Orléans), ce qui lui permet d’être accueillie au Centre de Biophysique Moléculaire (CNRS Orléans) en tant qu’artiste invitée.
Chloé Jeanne explore le vivant, crée des biomatériaux. Ses œuvres sont à la croisée de la recherche scientifique et du design. Elle élabore des installations et des sculptures prises dans des environnements sensibles de grande intensité.
Espace, objets, odeurs, organismes vivants forment un vocabulaire qu’elle déploie dans un récit qui joue avec les ambiguïtés de la perception. Faire pousser son matériau, pouvoir lui donner forme, être à l’écoute de ses besoins, en connaître les qualités et faiblesses, tous ces éléments créent une relation presque intime entre l’artiste et la matière.
Le travail de Chloé Jeanne, au croisement de la science, du design et des arts, permet de remettre en question et changer nos approches anthropocentrées.
Ils jouent, au gré de la température, de l’humidité, de la lumière, des flux d’air, sur ce sol artificiel improvisé par l’artiste, des morceaux de moquette, qu’elle a malicieusement surnommés tapis d’éveil.
Les capsules olfactives sont des dispositifs visuels et olfactifs crées à partir des champignons. Elles s’ancrent dans une volonté de proposer des nouveaux modes de connexion entre les êtres.
De par sa composition et de par l’usage du mycélium qui, dans son milieu naturel, la forêt, entre en symbiose avec la pierre autant qu’avec les éléments constitutifs de son environnement, celui-ci invite le spectateur à interroger sa posture et à se reconnecter aux éléments qui l’entourent.
Un dispositif trans-sensoriel qui donne à sentir, voir et percevoir, se faisant médiateur entre le corps du sujet, sa mémoire, ses émotions et son interaction avec les autres.
Les Prototaxites, colonnes sont le résultat d’une recherche plastique et scientifique autour du champignon. Elles sont inspirées d’une curiosité scientifique : les prototaxites. Ils seraient une étrangeté de la nature, mi champignon mi arbre.
Un réelle symbiose entre des multiples organismes qui aurait donné vie à des édifices de plus de 8 m de hauteur. Ici les Prototaxites, colonnes surgissent de terre, le mycélium vient à notre rencontre.
Les changements d’état sont fascinants. Les liquides saturés de sulfate cuivre, de sel, de sucre, de soufre et d’acide citrique se figent, cristallisent, cohabitent sur un seul et même support, le verre.
Le temps de la cristallisation les matières premières s’apprivoisent et déterminent leur place. Elles s’organisent ou parfois sèment le chaos et débordent… Les formes se font et se défont.
Les cristaux deviennent alors les témoins des changements de température et de luminosité. Leurs gammes chromatiques ainsi que leurs formes évoluent en fonction du temps et de leur environnement. Les peintures solubles s’altèrent, se transforment, évoluent, vivent au fil du temps.
Chardons est une installation produite par le processus de développement de moisissures, elle envahit l’espace tel un nid d’insectes qui s’accroît. De la même manière l’enduit appliqué et le conditionnement qui lui est imposé permet aux moisissures de se développer et d’en modifier l’aspect et les couleurs.